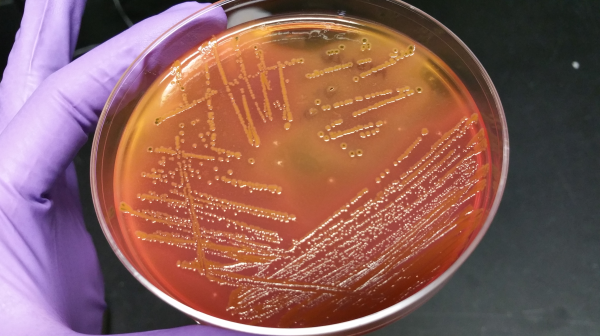

Pamela Ruegg
David J. Ellis Chair in Antimicrobial Resistance
Large Animal Clinical Sciences
College of Veterinary Medicine
Related Work
-
Optimizing mastitis treatment costs using benchmarking data
Published on August 6, 2025
-
Selective dry cow therapy: One tool to reduce antibiotics on your dairy farm
Published on February 20, 2025
-
MSU honors Dutch Meadows Dairy as 2025 Dairy Farm of the Year
Published on February 3, 2025
-
MSU Dairy Farm recognized as one of nation’s best for milk quality, herd health
Published on January 16, 2025
-
New bilingual video series aims to reduce the spread of antibiotic resistant bacteria
Published on June 12, 2024
-
MSU to host virtual field day on practical strategies for responsible use of antimicrobials in livestock production
Published on October 8, 2021
-
The economic impact of duration of antibiotic treatments for mastitis
Published on February 28, 2021
-
New Meadows Endowed Chair for Dairy Management named
Published on February 17, 2020
-
MSU scientists team up to study bovine microbiome role in antibiotic resistant bacteria
Published on April 17, 2019

Print
Print Email
Email